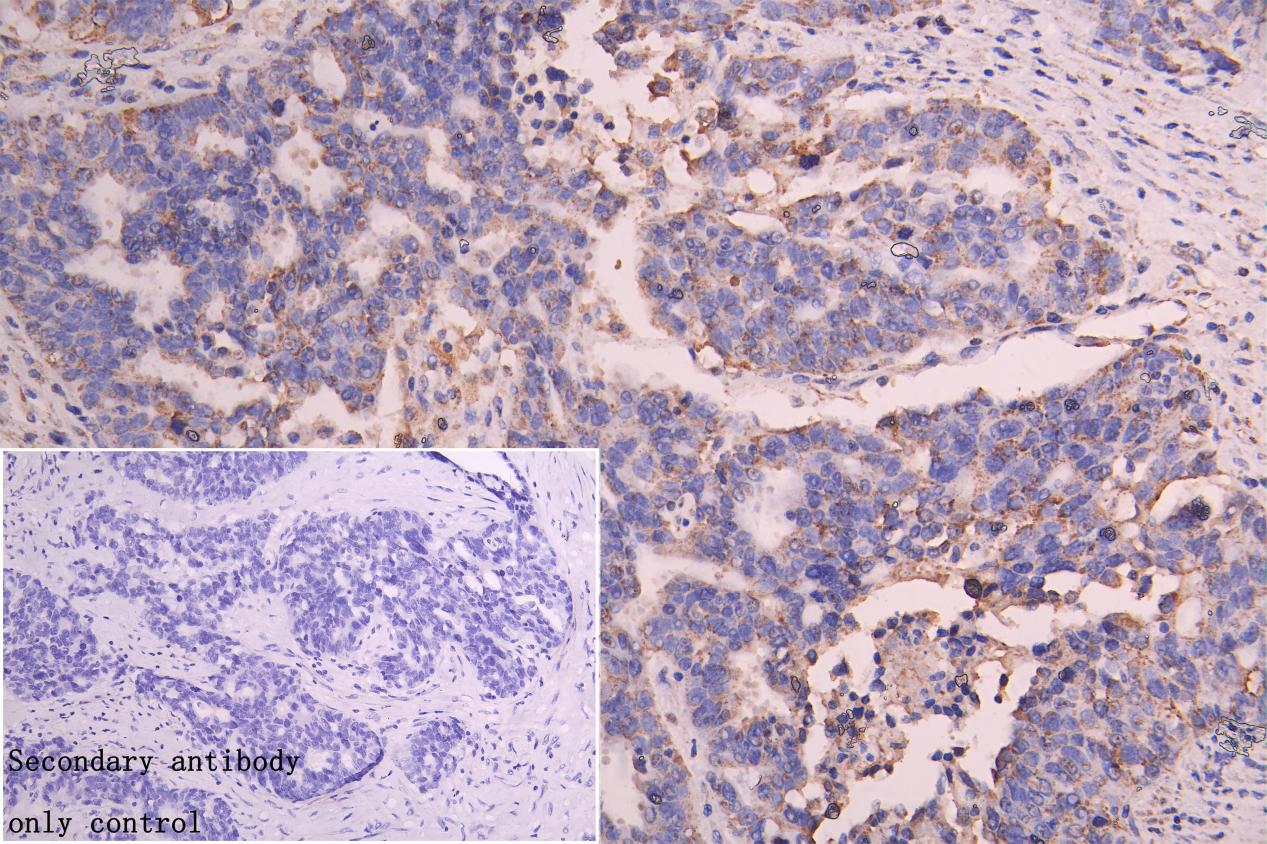

SLC25A51 Antibody
-
中文名稱:SLC25A51兔多克隆抗體
-
貨號:CSB-PA875649LA01HU
-
規(guī)格:¥440
-
圖片:
-
IHC image of CSB-PA875649LA01HU diluted at 1:300 and staining in paraffin-embedded human endometrial cancer performed on a Leica BondTM system. After dewaxing and hydration, antigen retrieval was mediated by high pressure in a citrate buffer (pH 6.0). Section was blocked with 10% normal goat serum 30min at RT. Then primary antibody (1% BSA) was incubated at 4°C overnight. The primary is detected by a Goat anti-rabbit polymer IgG labeled by HRP and visualized using 0.05% DAB. Secondary antibody only control: uses 1% BSA instead of primary antibody
-
-
其他:
產(chǎn)品詳情
-
產(chǎn)品描述:
The SLC25A51 polyclonal antibody was generated in a rabbit by injecting the recombinant human solute carrier family 25 member 51 protein (1-35aa), triggering an immune response. After collection of the resulting rabbit blood, protein G affinity chromatography was performed to refine the SLC25A51 polyclonal antibody, resulting in a purity level of more than 95%.
This high-purity SLC25A51 antibody has been shown to react with both human and mouse samples and has undergone thorough validation for use in WB, IF, and IHC applications, allowing for the detection of the presence of SLC25A51 protein and visualization of its distribution and localization.
-
產(chǎn)品名稱:Rabbit anti-Homo sapiens (Human) SLC25A51 Polyclonal antibody
-
Uniprot No.:
-
基因名:SLC25A51
-
別名:SLC25A51; MCART1; Mitochondrial nicotinamide adenine dinucleotide transporter SLC25A51; Mitochondrial NAD(+ transporter SLC25A51; Mitochondrial carrier triple repeat protein 1; Solute carrier family 25 member 51
-
宿主:Rabbit
-
反應(yīng)種屬:Human
-
免疫原:Recombinant Human Solute carrier family 25 member 51 protein (1-35AA)
-
免疫原種屬:Homo sapiens (Human)
-
標(biāo)記方式:Non-conjugated
本頁面中的產(chǎn)品,SLC25A51 Antibody (CSB-PA875649LA01HU),的標(biāo)記方式是Non-conjugated。對于SLC25A51 Antibody,我們還提供其他標(biāo)記。見下表:
-
克隆類型:Polyclonal
-
抗體亞型:IgG
-
純化方式:>95%, Protein G purified
-
濃度:It differs from different batches. Please contact us to confirm it.
-
保存緩沖液:Preservative: 0.03% Proclin 300
Constituents: 50% Glycerol, 0.01M PBS, PH 7.4 -
產(chǎn)品提供形式:Liquid
-
應(yīng)用范圍:ELISA, IHC
-
推薦稀釋比:
Application Recommended Dilution IHC 1:200-1:500 -
Protocols:
-
儲存條件:Upon receipt, store at -20°C or -80°C. Avoid repeated freeze.
-
貨期:Basically, we can dispatch the products out in 1-3 working days after receiving your orders. Delivery time maybe differs from different purchasing way or location, please kindly consult your local distributors for specific delivery time.
-
用途:For Research Use Only. Not for use in diagnostic or therapeutic procedures.
引用文獻(xiàn)
- BACH1 deficiency improves placental angiogenesis via SLC25A51-mediated mitochondrial NAD+ transport in intrahepatic cholestasis of pregnancy S Li, W Zhu, Z Xing, D Chen, H Zhao, Y Zhang,Molecular Medicine,2025
- SLC25A51 promotes tumor growth through sustaining mitochondria acetylation homeostasis and proline biogenesis Y Li,Cell death and differentiation,2023
- MCART1/SLC25A51 is required for mitochondrial NAD transport N Kory,Science Advances,2020
相關(guān)產(chǎn)品
靶點(diǎn)詳情
-
功能:Mitochondrial membrane carrier protein that mediates the import of NAD(+) into mitochondria. Mitochondrial NAD(+) is required for glycolysis and mitochondrial respiration. Compared to SLC25A52, SLC25A51-mediated transport is essential for the import of NAD(+) in mitochondria.
-
亞細(xì)胞定位:Mitochondrion inner membrane; Multi-pass membrane protein.
-
蛋白家族:Mitochondrial carrier (TC 2.A.29) family
-
數(shù)據(jù)庫鏈接:
Most popular with customers
-
-
YWHAB Recombinant Monoclonal Antibody
Applications: ELISA, WB, IHC, IF, FC
Species Reactivity: Human, Mouse, Rat
-
Phospho-YAP1 (S127) Recombinant Monoclonal Antibody
Applications: ELISA, WB, IHC
Species Reactivity: Human
-
-
-
-
-